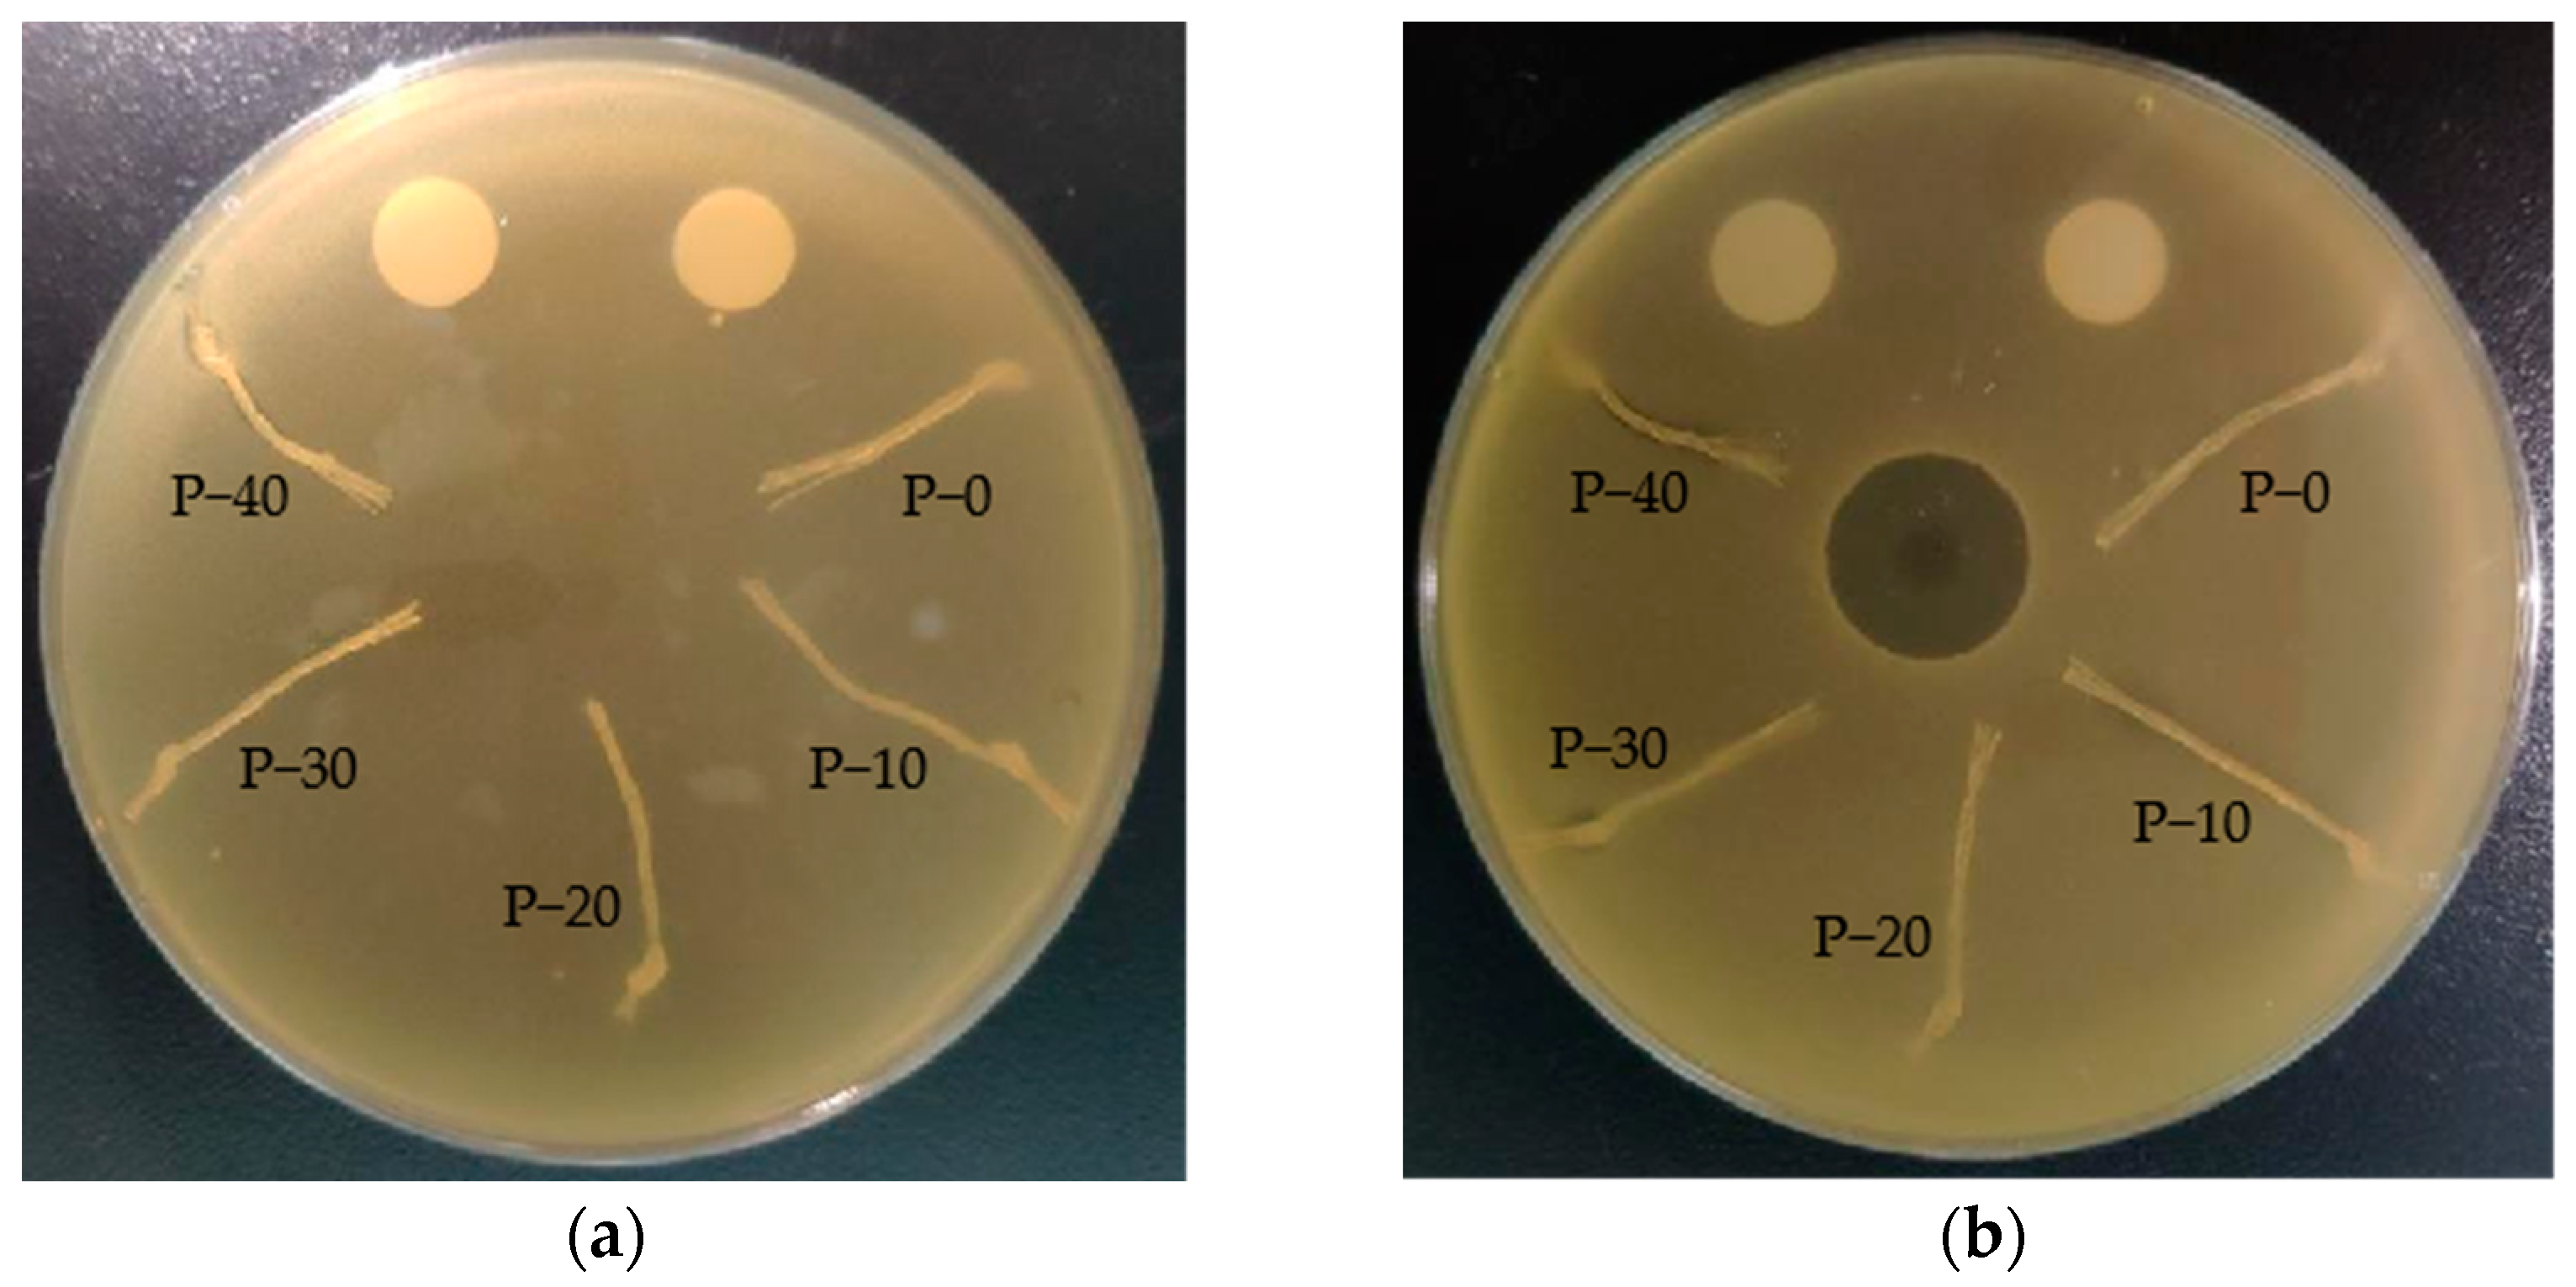
Polymers 15 01521 g009 Polymers 15 01521 g009

Environmentally Friendly and Broad–Spectrum Antibacterial Poly(hexamethylene guanidine)–Modified Polypropylene and Its Antifouling Application
Abstract
1. Introduction
2. Materials and Methods
2.1. Materials
2.2. Preparation of PP–g–PHMG/PP Monofilaments
2.3. Characterization
3. Results and Discussion
3.1. Fourier Transform Infrared (FTIR) Analysis of PP–g–PHMG/PP Monofilaments
3.2. Effect of PP–g–PHMG on Crystallization and Relaxation Behavior
3.3. Analysis of the Relationship between Composition, Mechanical Properties, and Water Absorption
3.4. Antibacterial and Antifouling Properties of Fishing Net Fibers Grafted with PHMG
4. Conclusions
Author Contributions
Funding
Institutional Review Board Statement
Data Availability Statement
Conflicts of Interest
References
- Techawinyutham, L.; Frick, A.; Siengchin, S. Polypropylene/maleic anhydride grafted polypropylene (MAgPP)/coconut fiber composites. Adv. Mech. Eng. 2016, 8, 1–9. [Google Scholar] [CrossRef]
- Shi, J.G.; Chen, X.X.; Liu, Y.L.; Wang, L. Comparative study on abrasive resistance of compound fishing PP/PA and common PP monofilaments. Mar. Fish. 2011, 33, 335–345. [Google Scholar]
- Shi, J.G.; Liu, Y.L.; Ma, H.Y. Study on fishing modified 4–strand PP/PE ropes. Mod. Fish. Inf. 2010, 25, 16–19. [Google Scholar]
- Xie, C.H.; Guo, H.S.; Zhao, W.Q.; Zhang, L. Environmentally friendly marine antifouling coating based on a synergistic strategy. Langmuir 2020, 36, 2396–2402. [Google Scholar] [CrossRef]
- Liu, W.B.; Gao, Y.T.; Jing, Q.Q.; Gao, Y.H.; Li, W.S.; Jia, Y.D.; Huang, B. Investigation of Biological Anti–Attachment in Net of Off–Shore Sea–Cage and Pen. J. Fish. China 2019, 6, 126–130. [Google Scholar]
- Shi, J.G.; Yu, W.W.; Zhao, K.; Liu, Y.L.; Wang, L.; Xu, A.C.; Wang, L.Q.; Chang, X.Y.; Wang, Y.; Sun, B.; et al. Progress on research of antifouling technology of offshore cage netting. J. Fish. China 2020, 45, 472–485. [Google Scholar]
- Man, X.D.; Song, X.F.; Huang, Z.T.; Dong, D.P. Design and simulation test of rotating disc cage cleaning device. Fish. Mod. 2019, 46, 22–28. [Google Scholar]
- Nie, Z.W.; Wang, L.; Liu, Y.L.; Shi, J.G.; Min, M.H.; Yu, W.W.; Chen, X.X.; Wang, L.M. Development and application of fishery copper alloy netting. Mar. Fish. 2016, 38, 329–336. [Google Scholar]
- Kartal, G.E.; Sariisik, A.M. Modifying of UHMWPE fishing nets with layer–by–layer deposition method for antifouling properties. J. Coat. Technol. Res. 2020, 18, 163–171. [Google Scholar] [CrossRef]
- Ashraf, P.M.; Edwin, L. Nano copper oxide incorporated polyethylene glycol hydrogel: An efficient antifouling coating for cage fishing net. Int. Biodeterior. Biodegrad. 2016, 115, 39–48. [Google Scholar] [CrossRef]
- Jin, H.C.; Wang, J.F.; Tian, L.M.; Gao, M.Y.; Zhao, J.; Ren, L.Q. Recent advances in emerging integrated antifouling and anticorrosion coatings. Mater. Des. 2022, 23, 110307. [Google Scholar] [CrossRef]
- Lainioti, G.C.; Tsapikouni, A.; Druvari, D.; Avramidis, P.; Prevedouros, I.; Glaropoulos, A.; Kallitsis, J.K. Environmentally friendly cross–Linked antifouling coatings based on dual antimicrobial action. Int. J. Mol. Sci. 2021, 22, 4658. [Google Scholar] [CrossRef]
- Cao, P.; Liu, D.; Zhang, Y.B.; Xiao, F.; Yuan, C.Q.; Liang, F.; Liu, X.D.; Zhang, C. Dopamine–assisted sustainable antimicrobial peptide coating with antifouling and anticorrosion properties. Appl. Surf. Sci. 2022, 589, 153019. [Google Scholar] [CrossRef]
- Xu, X.Y.; Chen, R.R.; Sun, G.H.; Yu, J.; Liu, Q.; Liu, J.Y.; Lin, C.G.; Liu, P.L.; Wang, J. A facile hydrophilic modification strategy initiated by flame treatment of silicone coatings for marine antifouling application. Appl. Surf. Sci. 2022, 580, 152177. [Google Scholar] [CrossRef]
- Zhou, J.L.; Wang, Y.P.; Pan, W.N.; Xiang, H.X.; Li, P.; Zhou, Z.; Zhu, M.F. High thermal stability Cu2O@OZrP micro–nano hybrids for melt–spun excellent antibacterial activity polyester fibers. J. Mater. Sci. Technol. 2021, 81, 58–66. [Google Scholar] [CrossRef]
- Kasiri, M.B.; Safapour, S. Natural dyes and antimicrobials for green treatment of textiles. Environ. Chem. Lett. 2014, 12, 1–13. [Google Scholar] [CrossRef]
- Lotfalizadeh, M.; Badpeyma, M.; Shakeri, A.; Soheili, V.; Nourbakhsh, F. From plants to antimicrobials: Natural products against bacterial membranes. Phytother. Res. 2022, 36, 33–52. [Google Scholar]
- Strasakova, M.; Pummerova, M.; Filatova, K.; Sedlarik, V. Immobilization of caraway essential oil in a polypropylene matrix for antimicrobial modification of a polymeric surface. Polymers 2021, 13, 906. [Google Scholar] [CrossRef] [PubMed]
- Belkhir, K.; Pillon, C.; Cayla, A.; Campagne, C. Antibacterial textile based on hydrolyzed milk casein. Materials 2021, 14, 251. [Google Scholar] [CrossRef] [PubMed]
- Zhang, W.; Cheng, W.; Ziemann, E.; Be’er, A.; Lu, X.L.; Elimelech, M.; Bernstein, R. Functionalization of ultrafiltration membrane with polyampholyte hydrogel and graphene oxide to achieve dual antifouling and antibacterial properties. J. Membr. Sci. 2018, 565, 293–302. [Google Scholar] [CrossRef]
- Yu, W.W.; Liu, Y.L.; Wang, L.; Shi, J.G. Cu nanoparticle–modified high–density polyethylene monofilament and its antifouling performance on fishing netting. Int. J. Polym. Sci. 2019, 2019, 7250348. [Google Scholar] [CrossRef]
- Zhang, W.; Huang, H.; Bernstein, R. Zwitterionic hydrogel modified reduced graphene oxide/ZnO nanocomposite blended membrane with high antifouling and antibiofouling performances. J. Colloid Interface Sci. 2022, 613, 426–434. [Google Scholar] [CrossRef]
- Zhang, G.Y.; Xiao, Y.; Yin, Q.T.; Yan, J.W.; Zang, C.F.; Zhang, H.Y. In Situ Synthesis of Silver Nanoparticles on Amino–Grafted Polyacrylonitrile Fiber and Its Antibacterial Activity. Nanoscale Res. Lett. 2021, 16, 36. [Google Scholar] [CrossRef]
- El Saeed, A.M.; Abd El–Fattah, M.; Azzam, A.M.; Dardir, M.M.; Bader, M.M. Synthesis of cuprous oxide epoxy nanocomposite as an environmentally antimicrobial coating. Int. J. Biol. Macromol. 2016, 89, 190–197. [Google Scholar] [CrossRef]
- Chen, R.R.; Li, Y.K.; Tang, L.; Yang, H.C.; Lu, Z.T.; Wang, J.; Liu, L.H.; Takahashi, K. Synthesis of zinc–based acrylate copolymers and their marine antifouling application. RSC. Adv. 2017, 7, 40020–40027. [Google Scholar] [CrossRef]
- Sun, J.; Li, S.F.; Xiang, Y.X. Preparation of Fe3O4@TiO2 blended PVDF membrane by magnetic coagulation bath and its permeability and pollution resistance. J. Mater. Res. Technol. 2020, 9, 4951–4967. [Google Scholar] [CrossRef]
- Jain, A.; Duvvuri, L.S.; Farah, S.; Beyth, N.; Domb, A.J.; Khan, W. Antimicrobial polymers. Adv. Healthcare Mater. 2014, 3, 1969–1985. [Google Scholar] [CrossRef] [PubMed]
- Yin, S.S.; Zhang, X.; Meng, Y.; Su, J.J.; Han, J. Design and synthesis of bactericidal block copolymer for preparing durably antibacterial PA6 fibre. Micro. Nano. Lett. 2020, 15, 47–51. [Google Scholar] [CrossRef]
- Zhao, R.F.; Tan, P.F.; Han, Y.T.; Yang, F.; Shi, Y.D.; Zhu, P.X.; Tan, L. Preparation and performance evaluation of antibacterial melt–spun polyurethane fiber loaded with berberine hydrochloride. Polymers 2021, 13, 2336. [Google Scholar] [CrossRef]
- Nosova, N.; Roiter, Y.; Samaryk, V.; Varvarenko, S.; Voronov, S.; Stetsyshyn, Y.; Minko, S.; Stamm, M.; Voronov, S. Polypropylene surface peroxidation with heterofunctional polyperoxides. Macromol. Symp. 2004, 210, 339–348. [Google Scholar] [CrossRef]
- Wang, Y.; Yu, W.W.; Shu, A.Y.; Shi, J.G.; Zhang, M. Polypropylene–grafted poly(hexamethylene guanidine)/modified polyethylene monofilament and its antimicrobial performance. Int. J. Polym. Sci. 2020, 2020, 6416230. [Google Scholar] [CrossRef]
- Bhalani, D.V.; Trivedi, J.S.; Jewrajka, S.K. Selective grafting of morphologically modified poly(vinylidene fluoride) ultrafiltration membrane by poly(acrylic acid) for inducing antifouling property. Appl. Surf. Sci. 2021, 544, 148905. [Google Scholar] [CrossRef]
- Zhou, Z.X.; Wei, D.F.; Guan, Y.; Zheng, A.N.; Zhong, J.J. Damage of Escherichia coli membrane by bactericidal agent polyhexamethylene guanidine hydrochloride: Micrographic evidences. J. Appl. Microbiol. 2010, 108, 898–907. [Google Scholar] [CrossRef] [PubMed]
- Gong, W.L.; Wei, D.F.; Zhang, S.T.; Jiang, Y.C.; Ye, J.Y.; Zheng, A.N.; Guan, Y. Nonleaching antimicrobial poly(vinyl alcohol)/polyhexamethylene guanidine hydrochloride hydrogels reinforced by hydrogen bond. Polym. Adv. Technol. 2020, 31, 3238–3246. [Google Scholar] [CrossRef]
- Ye, S.J.; Wei, D.F.; Xu, X.; Guan, Y.; Zheng, A. Surface antimicrobial modification of polyamide by poly(hexamethylene guanidine) hydrochloride. Polym. Adv. Technol. 2020, 31, 1847–1856. [Google Scholar] [CrossRef]
- Lin, J.H.; Pan, Y.J.; Liu, C.F.; Huang, C.L.; Hsieh, C.T.; Chen, C.K.; Lin, Z.I.; Lou, C.W. Preparation and compatibility evaluation of polypropylene/high density polyethylene polyblends. Materials 2015, 8, 8850–8859. [Google Scholar] [CrossRef] [PubMed]
- Shi, Y.H.; Dou, Q. Effect of β–nucleating agent on the crystallization, mechanical properties, and heat resistance of injection–molded isotactic polypropylene. J. Macromol. Sci. 2013, 52, 476–488. [Google Scholar] [CrossRef]
- Hafidz, N.S.; Rehan, M.S.; Mokhtar, H.B. Effect of alkaline treatment on water absorption and thickness swelling of natural fibre reinforced unsaturated polyester composites. Mater. Today Proc. 2022, 48, 720–727. [Google Scholar] [CrossRef]
- Roy, A.; Joshi, M.; Butola, B.S. Antimicrobial performance of polyethylene nanocomposite monofilaments reinforced with metal nanoparticles decorated montmorillonite. Colloids Surf. B 2019, 178, 87–93. [Google Scholar] [CrossRef] [PubMed]
- Wei, D.F.; Ding, Y.F.; Wang, T.W. Preparation of nonleaching antimicrobial polypropylene wax and its application in polypropylene. J. Appl. Polym. Sci. 2016, 134, 44190. [Google Scholar] [CrossRef]
- Cao, W.; Wei, D.F.; Zheng, A.N.; Guan, Y. Surface enrichment and nonleaching antimicrobial performance of polypropylene grafted poly(hexamethylene guanidine) (PP–g–PHMG) in poly(ethylene terephthalate)/PP–g–PHMG. Eur. Polym. J. 2019, 118, 231–238. [Google Scholar] [CrossRef]
- Kouini, B.; Serier, A. Properties of polypropylene/polyamide nanocomposites prepared by melt processing with a PP–g–MAH compatibilizer. Mater. Des. 2012, 34, 313–318. [Google Scholar] [CrossRef]
- Li, J.; Zhang, S.; Chu, L.; Zou, H.; Zhang, L.Y. Modification of polypropylene by PHMG/MMT composite antibacterial agents. China Synth. Resin Plast. 2012, 29, 9–12. [Google Scholar]
- Dang, W.J.; Song, Y.M.; Wang, Q.W.; Wang, H.W. Interfacial compatibility and toughening modification of wood fiber–polypropylene composites. J. Beijing For. Univ. 2007, 29, 133–137. [Google Scholar]
- Bu, F.H.; Wang, H.W.; Wang, Q.W. Effect of MA–POE on mechanical properties of wood flour/polypropylene composites. J. For. Res. 2010, 38, 80–83. [Google Scholar]
- Yu, W.W.; Shi, J.G.; Chen, X.X.; Min, M.H.; Wang, L.; Song, W.H. The mechanical properties and dynamic mechanical behavior of MHMPE/iPP/EPDM fishery monofilaments. J. Fish. China 2017, 41, 473–479. [Google Scholar]
- Zhang, Z.W.; Yang, J.J.; Wu, Q.Y.; Wu, M.Y.; Zhang, J.A.; Liu, J.Y. Preparation and properties of UV curable PHMG–based antibacterial nonionic waterborne polyurethane. Fine Chem. 2020, 9, 1799–1805. [Google Scholar]
- Qian, L.Y.; Xiao, H.N.; Zhao, G.L.; He, B.H. Synthesis of modified guanidine–based polymers and their antimicrobial activities Revealed by AFM and CLSM. ACS Appl. Mater. Interfaces 2011, 3, 1895–1901. [Google Scholar] [CrossRef] [PubMed]
- Chen, F.X.; Ding, X.X.; Jiang, Y.C.; Guan, Y.; Wei, D.F.; Zheng, A.N.; Xu, X. Permanent antimicrobial poly(vinylidene fluoride) prepared by chemical bonding with poly(hexamethylene guanidine). ACS Omega 2020, 5, 10481–10488. [Google Scholar] [CrossRef]

| Wavenumbers (cm−1) | Groups |
|---|---|
| 3285 | N–H 1 |
| 3187 | N–H 1 |
| 1728 | C = O 2 |
| 1640 | C = N 1 |
| 1456 | CH2 3 |
| 1378 | CH3 3 |
| 1168 | CH3 3 |
| 973 | CH3 3 |
| Samples | Tm (°C) | ΔHf obs (J/g) | Tc (°C) | Xc (%) |
|---|---|---|---|---|
| P–0 | 170.2 | 96.7 | 119.3 | 50.9 |
| P–10 | 170.3 | 101.8 | 124.8 | 53.6 |
| P–20 | 170.2 | 103.0 | 124.3 | 54.2 |
| P–30 | 170.8 | 106.0 | 124.6 | 55.8 |
| P–40 | 169.4 | 106.4 | 125.0 | 56.0 |
Disclaimer/Publisher’s Note: The statements, opinions and data contained in all publications are solely those of the individual author(s) and contributor(s) and not of MDPI and/or the editor(s). MDPI and/or the editor(s) disclaim responsibility for any injury to people or property resulting from any ideas, methods, instructions or products referred to in the content. |
© 2023 by the authors. Licensee MDPI, Basel, Switzerland. This article is an open access article distributed under the terms and conditions of the Creative Commons Attribution (CC BY) license (https://creativecommons.org/licenses/by/4.0/).
Share and Cite
Qiu, B.; Wang, M.; Yu, W.; Li, S.; Zhang, W.; Wang, S.; Shi, J. Environmentally Friendly and Broad–Spectrum Antibacterial Poly(hexamethylene guanidine)–Modified Polypropylene and Its Antifouling Application. Polymers 2023, 15, 1521. https://doi.org/10.3390/polym15061521
Qiu B, Wang M, Yu W, Li S, Zhang W, Wang S, Shi J. Environmentally Friendly and Broad–Spectrum Antibacterial Poly(hexamethylene guanidine)–Modified Polypropylene and Its Antifouling Application. Polymers. 2023; 15(6):1521. https://doi.org/10.3390/polym15061521
Chicago/Turabian StyleQiu, Biwei, Meng Wang, Wenwen Yu, Shouhu Li, Wenyang Zhang, Shuting Wang, and Jiangao Shi. 2023. "Environmentally Friendly and Broad–Spectrum Antibacterial Poly(hexamethylene guanidine)–Modified Polypropylene and Its Antifouling Application" Polymers 15, no. 6: 1521. https://doi.org/10.3390/polym15061521
APA StyleQiu, B., Wang, M., Yu, W., Li, S., Zhang, W., Wang, S., & Shi, J. (2023). Environmentally Friendly and Broad–Spectrum Antibacterial Poly(hexamethylene guanidine)–Modified Polypropylene and Its Antifouling Application. Polymers, 15(6), 1521. https://doi.org/10.3390/polym15061521

